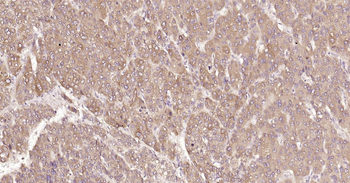
Human CRIM1 Ready-To-Use IHC Kit

You have no items in your shopping cart.
Description
Images & Validation
−
| Application Notes |
|---|
Key Properties
−| Source | Sf9, Baculovirus |
|---|---|
| Purity | Greater than 90.0% as determined by SDS-PAGE. |
| Protein Sequence | QPSVSPGEPS PPSIHPGKSD LIVRVGDEIR LLCTDPGFVK WTFEILDETN ENKQNEWITE KAEATNTGKY TCTNKHGLSN SIYVFVRDPA KLFLVDRSLY GKEDNDTLVR CPLTDPEVTN YSLKGCQGKP LPKDLRFIPD PKAGIMIKSV KRAYHRLCLH CSVDQEGKSV LSEKFILKVR PAFKAVPVVS VSKASYLLRE GEEFTVTCTI KDVSSSVYST WKRENSQTKL QEKYNSWHHG DFNYERQATL TISSARVNDS GVFMCYANNT FGSANVTTTL EVVDKGFINI FPMINTTVFV NDGENVDLIV EYEAFPKPEH QQWIYMNRTF TDKWEDYPKS ENESNIRYVS ELHLTRLKGT EGGTYTFLVS NSDVNAAIAF NVYVNTKPEI LTYDRLVNGM LQCVAAGFPE PTIDWYFCPG TEQRCSASVL PVDVQTLNSS GPPFGKLVVQ SSIDSSAFKH NGTVECKAYN DVGKTSAYFN FAFKGNNKEQ IHPHTLFTPL EHHHHHH |
Storage & Handling
−| Storage | Stability: Store at 4°C if entire vial will be used within 2-4 weeks.Store, frozen at -20°C for longer periods of time. For long term storage it is recommended to add a carrier protein (0.1% HSA or BSA).Avoid multiple freeze-thaw cycles |
|---|---|
| Form/Appearance | Sterile Filtered colorless solution. |
| Buffer/Preservatives | KIT protein solution (0.25mg/ml) contains Phosphate Buffered Saline (pH 7.4) and 10% glycerol. |
| Expiration Date | 6 months from date of receipt. |
| Disclaimer | For research use only |
Alternative Names
−Mast/stem cell growth factor receptor Kit, SCFR, Piebald trait protein, PBT, Proto-oncogene c-Kit, Tyrosine-protein kinase Kit, p145 c-kit, v-kit Hardy-Zuckerman 4 feline sarcoma viral oncogene homolog, CD117.
Similar Products
−Human High Mobility Group Protein B1 (HMGB-1) ELISA Kit [orb1807472]
Human
31.25-2000pg/mL
13.7 pg/mL
48 T, 96 THuman Monocyte Chemotactic Protein 1 (MCP1) ELISA Kit [orb779110]
Human
15.63-1000 pg/mL
6.4 pg/mL
48 T, 96 THuman Ubiquitin Carboxyl Terminal Hydrolase L1 (UCHL1) ELISA Kit [orb781347]
Human
0.79-50 ng/mL
0.28 ng/mL
96 T, 48 T

Quality Guarantee
Explore bioreagents carefree to elevate your research. All our products are rigorously tested for performance. If a product does not perform as described on its datasheet, our scientific support team will provide expert troubleshooting, a prompt replacement, or a refund. For full details, please see our Terms & Conditions and Buying Guide. Contact us at support@biorbyt.com.
Documents Download
Datasheet
Product Information
Request a Document
Protocol Information
Protein Handling and Storage Guide
Protein Handling Guide
Human KIT Protein (orb429423)
Based on 0 reviews
Participating in our Biorbyt product reviews program enables you to support fellow scientists by sharing your firsthand experience with our products.
Login to Submit a Review